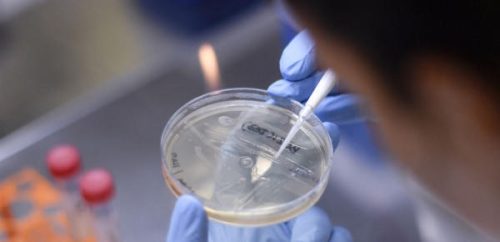

أصدرت منظمة الصحة العالمية تحذيرا خطيرا مع اكتشاف 4 حالات أخرى من جدري القرود في المملكة المتحدة.
ووفقا لوكالة الأمن الصحي في المملكة المتحدة، فإن الحالات الجديدة التي اكتشفت في لندن وشمال شرق إنجلترا، ليس لها صلة معروفة بالإصابات الثلاث السابقة.
وقالت منظمة الصحة العالمية في بيان لها: “أي مرض أثناء السفر أو عند العودة من منطقة موبوءة يجب إبلاغ أخصائي الصحة، بما في ذلك معلومات حول تاريخ السفر والتحصين الأخير. ويجب على المقيمين والمسافرين إلى البلدان الموبوءة تجنب الاتصال بالحيوانات المريضة (الميتة أو الحية) التي يمكن أن تؤوي فيروس جدري القردة (القوارض والجرابيات والقرود) ويجب عليهم الامتناع عن أكل أو التعامل مع الطرائد البرية (لحوم الطرائد).
ويجب التأكيد على أهمية نظافة اليدين باستخدام الصابون والماء، أو المطهرات التي تحتوي على الكحول. وبينما تمت الموافقة مؤخرا على لقاح وعلاج محدد لجدري القرود، في عامي 2019 و2022 على التوالي، فإن هذه الإجراءات المضادة ليست متاحة على نطاق واسع حتى الآن”.
كما أشارت UKHSA إلى أنه لم تزر أي من الحالات الجديدة بلدا يتوطن فيه فيروس جدري القرود، وهو فيروس يقتل ما يصل إلى 10% من السكان المصابين.
وقالت الدكتورة سوزان هوبكنز، كبيرة المستشارين الطبيين في UKHSA: “هذا نادر وغير معتاد. تشير الدلائل إلى أنه قد يكون هناك انتقال لفيروس جدري القردة في المجتمع، ينتشر عن طريق الاتصال الوثيق. نحن نحث بشكل خاص الرجال المثليين ومزدوجي الميل الجنسي على أن يكونوا على دراية بأي طفح جلدي أو آفات غير عادية والاتصال بخدمة الصحة الجنسية دون تأخير”.